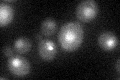
YNL206C
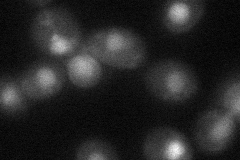
YNL206C
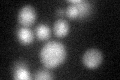
YNL206C
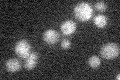
YNL206C

View description
Histone chaperone, involved in regulation of chromatin structure in both transcribed and silenced chromosomal regions; affects transcriptional elongation; has a role in regulation of Ty1 transposition
Localization:
Intensity:
Fold change:
Significance:
-
C’ GFP library in SD
nucleus20.94 -
N' NOP1pr-GFP in SD

nucleus111.41 -
N' TEF2pr-mCherry in SD

nucleus132.092 -
N' NATIVEpr-GFP in SD

nucleus41.9842 -
N' TEF2pr-VC and Cyto-VN in SD
nucleus35.1582 -
C’ GFP library in SD+DTT
nucleus18.610.88No -
C’ GFP library in SD+H2O2

nucleus20.320.97No -
C’ GFP library in Starvation Media
nucleus17.970.85No -
C’ GFP library on the background of Pup2-DaMP

nucleus -
C’ GFP library on the background of CCT mutant

nucleus19.43440.927794No
